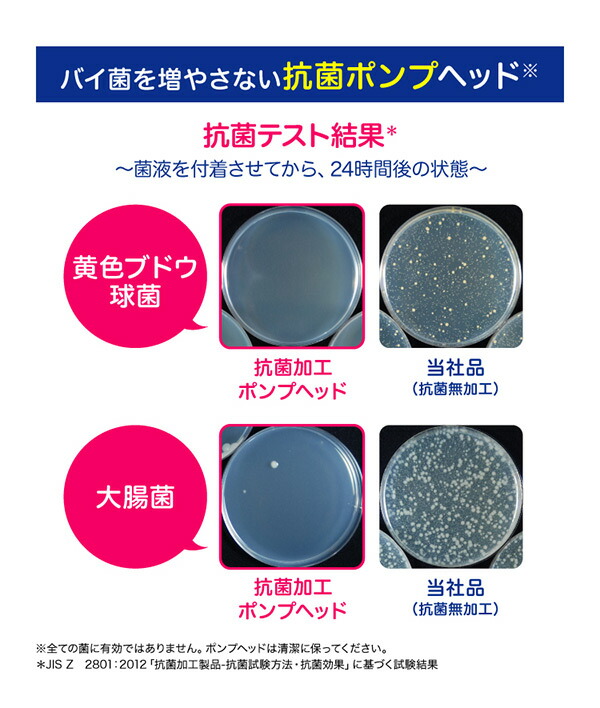

ビオレu 泡ハンドソープ 大容量 ポンプ 本体 500ml×3個 【医薬部外品】 ビオレユー ビオレ ハンドソープ 泡タイプ 泡 殺菌 除菌 消毒 弱酸性 石鹸 手洗い 手指洗浄剤 日本製 花王 Kao 【送料無料】
Pontaパス特典
サンキュー配送
2,499円(税込)
0ポイント(1%)
商品説明

| 花王 Kao ビオレu 泡ハンドソープ 大容量 ポンプ 本体 500ml×3個 【医薬部外品】 |
|
| 本体サイズ | 幅10×奥行10×高さ17.4cm 重量588g |
| 材質 | イソプロピルメチルフェノール*、水、ポリオキシエチレンラウリルエーテル硫酸アンモニウム(1E.O.)液、PG、エタノール、PEG6000、POEラウリルエーテル酢酸、グリセリルエチルヘキシルエーテル、アクリルアミド・アクリル酸・塩化ジメチルジアリルアンモニウム共重合体液、塩化トリメチルアンモニオヒドロキシプロピルヒドロキシエチルセルロース、エデト酸塩、乳酸、水酸化ナトリウム液、安息香酸塩、香料 *は「有効成分」無表示は「その他の成分」 |
| 仕様 | ●原産国:日本 |
| 商品説明 | ●500ml×3個セット ●素肌と同じ弱酸性のハンドソープ ●たっぷり使える大容量ポンプ ●手指のすみずみまで洗いやすい泡タイプ ●1プッシュでも洗浄中へたりにくい「ながもっち泡」 ●カサつきがちな手肌もうるおいを守ってやさしく洗浄 ●マイルドシトラスの香り ●抗菌ポンプヘッド採用 ●医薬部外品 |
| 商品 補足説明 |
YAMAZEN ヤマゼン 山善 通販 花王 Kao ビオレu ビオレユー ビオレ ハンドソープ 泡ハンドソープ 泡タイプ 泡 大容量 500ml 殺菌 除菌 消毒 弱酸性 石鹸 手洗い 手指洗浄剤 日本製 R7P14*3 |
レビュー
商品の評価:



-点(0件)
お店の情報
現在、多くのお客様よりお問い合わせをいただいており、順次回答を行っておりますが、通常よりお時間を要しております。申し訳ございません。
お店の評価:



-点(0件)
連絡・応対
-
配送スピード
-
梱包
-






















